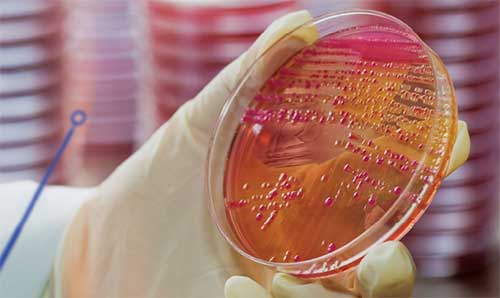

LabPro-MBT Software
Take a step forward in your antibiotic stewardship program with LabPro-MBT software.
LabPro-MBT is a convenient software solution that seamlessly combines accurate AST results from the DxM MicroScan WalkAway System with the rapid ID of the Bruker MALDI Biotyper® System*, enhancing workflow and improving clinical impact.
- Displays Bruker identification, biotype, score value and matching hints
- Applies AlertEX System rules to final identifications
- Transfers high-confidence Bruker identifications from LabPro-MBT to LIS (Figure 1)
Figure 1. LabPro-MBT Overview Diagram

Combines Bruker MALDI Biotyper identification with MicroScan MIC values.
Support truly Lean processing and boost MALDI-TOF productivity by combining LabPro-MBT with LabPro Connect. Eliminate non-value-added movement by executing all related activities right at your workstation.
- Perform target assignments, results management and LIS transmissions right from the technologist's bench
- Manage MALDI-TOF ID and MicroScan AST results where isolate workup occurs
Stay in sync with Bruker updates using the LabPro import feature.
- Enables import of new Bruker database updates into LabPro, including organism number (UUID), organism name and matching hints
- Allows user to apply therapy information to newly updated organisms, as appropriate, without the need for a LabPro software update
Requirements: |
|
Article Discover the Speed and Accuracy of MALDI-TOF
Explore the history of MALDI-TOF and its applications for advancing antimicrobial stewardship.
Read articleBrochure MicroScan Microbiology Systems Powered by LabPro
Make critical decisions with confidence: LabPro Information Manager helps deliver more efficient, accurate test results.
Download
Antibiogram Export Instructions and Tools
CLSI recommends the annual preparation of a cumulative antibiogram report to assist physicians in empiric therapy decisions. The Antibiogram Export Tool provides a template for managing data transferred from the LabPro Information Manager into Microsoft Excel, enabling you to create customized reports and charts specific to your institutional needs.
Antibiogram Export Tool V4.42 (2018)
Antibiogram Export Tool V4.42 (2019)
Click on link to redirect to the Technical Documents where tools and instruments can be downloaded (login required).
*MALDI Biotyper is the property of Bruker Daltonik GmbH.
English